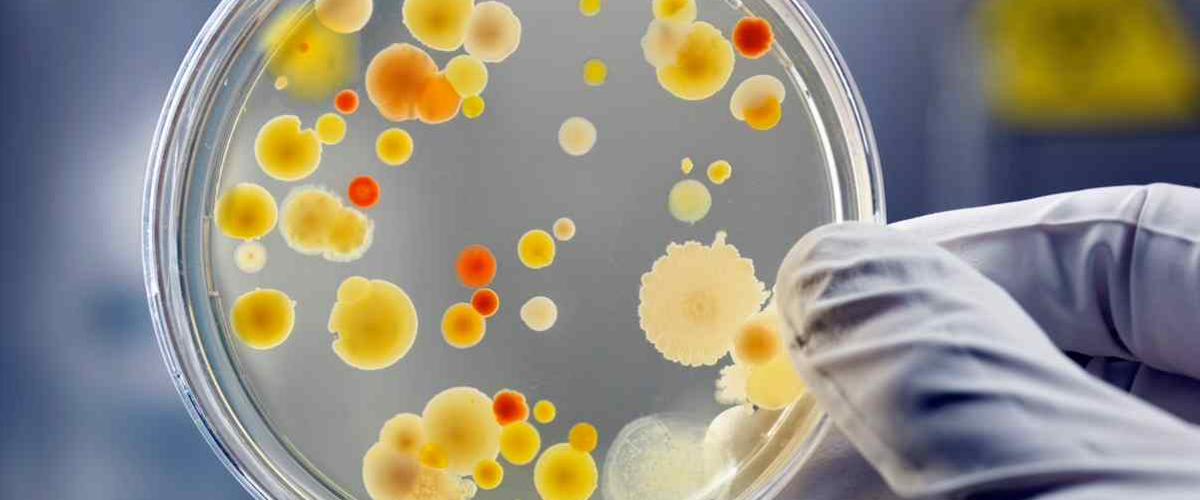
TODO:

Резистентность бактерий к антибактериальным препаратам относится в одной из главных проблем системы здравоохранения с непрерывно растущей смертностью. Исследователи из Медицинского колледжа Бэйлора стремились найти решение этой проблемы, поэтому стали проводить эксперименты с ципрофлоксацином — одним из наиболее часто назначаемых антибиотиков широкого спектра действия.
Из предыдущих исследований они знали, что когда бактерии оказываются в стрессовой среде из-за антибиотика, то запускают ряд реакций, приводящих к мутагенезу. Теперь они обнаружили, как именно это происходит.
«Мы были очень удивлены, обнаружив неожиданную молекулу, которая участвует в модулировании репарации ДНК», — прокомментировал автор работы Инь Чжай.
Обычно для этих целей клетки запускают производство специфических белков. Теперь ученые выяснили, что вместо активации определенных генов для синтеза новых белков запускается работа с ферментом РНК-полимеразой, который играет ключевую роль в их производстве.
Дальнейшие наблюдения показали, что присутствующий в бактериях нуклеотид ppGpp связывается с РНК-полимеразой для запуска восстановления. Именно в ходе этого процесса могут появляться мутации, которые изменяют исходную последовательность ДНК.
«Открытие указывает на новые возможности для предупреждения развития антибиотикорезистентности. Кроме того, результаты важны для изучения рака», — заявил Чжай. Оказалось, что разрушение бактериальной ДНК при взаимодействии с ципрофлоксацином во многом повторяет то, как противораковый препарат этопозид разрушает ДНК в опухолях. Таким образом, результаты также могут помочь в борьбе с резистентностью рака к химиотерапии.
Сегодня принято считать, что развитие резистентности к антибактериальным препаратам полностью зависит от уровня потребления лекарств конкретным человеком. Недавно ученые показали, что не менее важно окружение — резистентные гены могут передаваться на уровне населения.